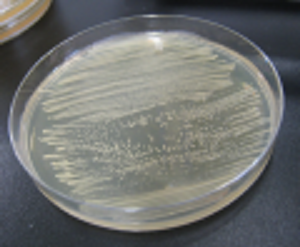

到达肠子的植物乳酸菌,使“吃着美味又健康”

采访了大学院(研究生院)医学牙科药学综合学科创生医科学专业 杉山政則(Sugiyama Masanori)教授
(采访人:校长办公室宣传小组 2008.3.11)
医学牙科药学综合学科杉山政则教授利用地面和国际宇宙站(ISS)获得的研究成果在美国生化学和分子生物学会的学术杂志Journal of Biological Chemistry(JBC)今年1月8日号(在去年11月电子版发表)上发表了。(2010.1.13)
>本校“通知”请阅览这里(该链接为日语页面)
杉山教授通过与中国酿造株式会社(总经理:白井浩一郎)的校企合作研究,开发出了依靠包括乳酸菌的微生物的发酵作用,既保护皮肤又洗脱污垢的洗脸液。(2010.11.9)
>本校举办新闻发布会的“通知”请阅览这里(该链接为日语页面)
研究活动概要
教授的研究领域主要是以微生物为材料的结构生物学。要知道组成蛋白质的氨基酸的排列信息比较容易,但是要从这个信息知道蛋白质的立体结构和功能是很困难的。因此教授希望推动分析对医药和医疗有用的蛋白质(酶)的X射线结晶的结构,从立体结构搞清楚蛋白质的功能。最近有人开玩笑地说教授只搞地区贡献的研究,放弃了基础研究,其实这两者良性循环,使采用结构生物学方法的基础研究非常顺利。
酪氨酸酶(粉红色)是催化合成形成皱纹和雀斑的黑色素的酶。在世界上首次通过X射线结晶结构分析决定了来自放线菌的酪氨酸酶与起到将铜离子(蓝色)送入酪氨酸酶的作用的Caddy蛋白质(灰色)的复合体的三维结构。

黑色素生成酶(酪氨酸酶)
这项研究是从“酒糟”开始的,并且从一个假说开始了这个“故事”。
2002年的秋天,广岛县的一个酿酒公司的领导来找杉山教授,他对教授说,“以前人们一直说酿酒师的皮肤又白又健康,我想有效利用酒糟,所以想请教授从科学的角度弄清酒糟的保健作用”。
当时杉山研究室在利用转基因技术培养产生黑色素的大肠杆菌。尝试加入酒糟(用公司提供的冷冻干燥法做的酒糟粉)进行培养,但是大肠杆菌制作不出黑色素。因此教授设立了一个假定,就是酒糟中有阻碍制作黑色素的酪氨酸酶的作用。于是正式开始寻找这个物质,最后找到了这个阻碍物质。
另外,在进一步研究酒糟的有用性时想到也许对特应性皮炎有效,于是在患该炎症的动物患部试着涂了含有酒糟的软膏,皮肤炎有所改善,也确定了有效物质。
植物乳酸菌
“不可能为可能”+“永不放弃”=梦想
听到这个信息,文部科学省知识集群创造事业(广岛生物集群)的协调员提出,“为了搞活广岛地区产业,教授的研究成果能否用于开发保健品”,并把项目定为“杉山项目”。
在同一时期,作为跨广岛县各技术中心的项目的一部分,成立了当地企业也参加的“食品功能开发研究会”。因为教授的项目被选为知识集群,因此杉山教授担任了理事。当地乳业公司的年轻研究人员问教授,“我们公司能做些什么?”。当时教授正在研究酒糟的保健作用,并且将酒糟粉放入通心粉,味道相当不错,所以就说,“如果将酒糟放入酸奶,也许能做出有保健作用的独特风味的食品”。那位研究人员第二天就来研究室拿酒糟粉,一周后拿来了试制品。
他说,加入少量的酒糟后,通常需要12小时的酸奶发酵时间缩短到了4小时左右。杉山教授认为酒糟中有帮助乳酸菌发酵的因子,建议那位研究人员再用植物乳酸菌试验一下。但是,因为植物乳酸菌很难在奶中繁殖,所以在酸奶业界通常认为植物乳酸菌做不出块状酸奶。那研究人员面有难色,但教授对他说,你就当作不可能成功,试一下吧。建议他在奶中添加微量的酒糟粉。因为教授认为,动物乳酸菌对胃酸和胆汁抵抗力很低,很难活着到达肠子。而植物乳酸菌能活着到达肠子,所以能生产与其他产品不同的产品。虽然还有要去除酒糟独特的味道的问题,但使用教授提供的从包括胡萝卜,梨,桃,葡萄等40多种蔬菜和水果分离出的植物乳酸菌,耗时1年半,做了数百次试验,终于生产出了能投放市场的“植物乳酸菌制作的块状酸奶”。这是决不放弃的杉山教授和当地小公司开发人员不懈的努力获得成功的瞬间。他们还将这个新的酸奶制造技术联合申请了专利,并于2004年10月推出了产品。
另一方面,发现在广岛产温州桔子的果汁中添加少量的谷氨酸的培养基上培养从胡萝卜分离的植物乳酸菌,则能产生大量的GABA(有降血压和抗精神压力的作用的氨基酸)。利用这项技术生产出了含GABA的酸奶。其他当地的食品企业还生产出了酱菜、梅酒、水果果冻等新的保健食品。因为是用于食品的,所以还确认了植物乳酸菌的安全性。
关于植物乳酸菌,与县内许多企业签订联合研究协议,还与国外企业(韩国大型乳业公司)签订了国际校企合作协议(提供专利技术),推进产业化。继韩国之后,今后计划与包括台湾的东亚和欧洲开展合作,推广广岛大学的植物乳酸菌发酵技术。
为了向全国销售这个项目产生的产品,设立了品牌“BioUniv广岛”,还设计了标识和标记。商品上标上了“Bio Univ Hiroshima”标记。这个标记是广岛大学注册的商标,表示是广岛大学提供的技术。杉山教授说,如果能把打上标记产品的一部分销售额作为大学的研究经费,以及作为对年轻研究人员的奖励就好了。

产品化的酸奶

Bio Univ Hiroshima标识・标记
目标是做对人有用的研究
杉山教授说,比如,在保健食品开发成功后,那个产品如果被认定为特保(特定保健食品),那就等于是厚生劳动省认可这个产品有益于健康。但是为了得到认定所需的试验费用,通常需要数千万至1亿日元左右,这对中小企业来说负担太重了。要制定能用较低的费用进行试验的制度,政府的作用很重要,还期待大学在研究开发方面发挥作用。教授认为要建立大学提供研究的种子,与企业一起开发技术,并申请专利,当实现产品化时就能收入专利费,并把一部分回馈给教师的制度。以前教授的想法是专心搞研究,支援中心企业。但是据说最近有许多人建议他自己办风险企业。
2007年4月,在杉山教授的努力下,在当时的碓井学科主任,弓削副校长,浅原附属医院院长的协助下,广岛大学研究生院医学牙科药学综合学科设立了企业捐助的“临床评估与分子营养科学教研室”。这是食品和医药品相关的当地16家企业与广岛大学部分有兴趣的校友的合作下实现的。这个教研室在大学附属医院医生的协助下,实施了验证食品保健作用的“人类临床试验”。期待通过在广岛大学进行保健食品的临床评估,能为广岛地区的食品制造企业和计划申请“特定保健食品”的国内其他企业作贡献。
最近,据说找到了产生有效阻碍幽门螺杆菌增殖的物质植物乳酸菌,并申请了相关专利。有望生产出理想的抗幽门螺杆菌的保健食品。

培养植物乳酸菌
成功找到了产生抗菌物质的植物乳酸菌!
在涂满某种细菌的寒天培养基上,放上浸有植物乳酸菌培养液的白色过滤纸,在37℃的条件下培养一晚。如果乳酸菌培养液中含有抗菌物质,则可以在过滤纸的周围观察到阻止细菌发育的圆圈(照片上看上去发黑的部分)。

杉山项目的标识和标记
(后记)
过了几天,传来了获得2008年度科学技术领域文部科学省大臣表彰(科学技术奖・技术部门)的好消息。教授,祝贺你。
科学技术奖(技术部门) 16个
获奖理由 利用酿造副产品和植物乳酸菌开发新酸奶
授奖仪式 2008年4月15日(周二) 虎之门牧歌
文部科学省关于获奖者等的网页 (该链接为日语页面)
http://warp.da.ndl.go.jp/info:ndljp/pid/286184/www.mext.go.jp/b_menu/houdou/20/03/08030609.htm
教授说,因为植物乳酸菌在哪里不知道,所以就像采集昆虫一样。他现在为了寻找乳酸菌,经常去植物园。他的话给我留下了深刻的印象。教授大概是牢记他母亲说的“做对他人有用的人”,今天也在忙着采集植物乳酸菌吧。但是最近教授好像忙得没有时间去了,所以如果能送给教授时间,那他一定会感谢的吧?在采访中,我突然冒出这样的想法。
4月1日,在(财)广岛产业振兴机构内设立了广岛大学和广岛县联合经营的“广岛技术转移中心”,教授就任主任,今后将越来越忙了。(O)